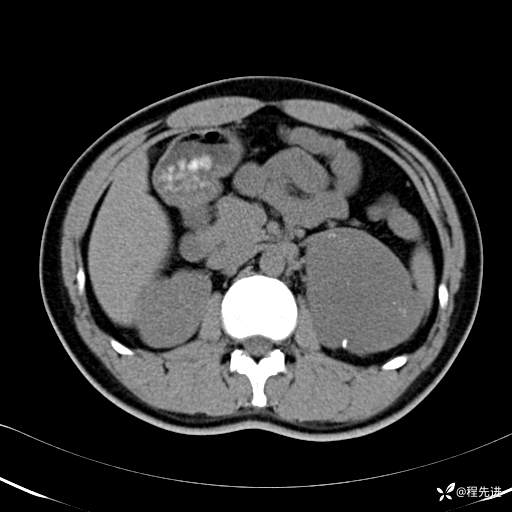
img
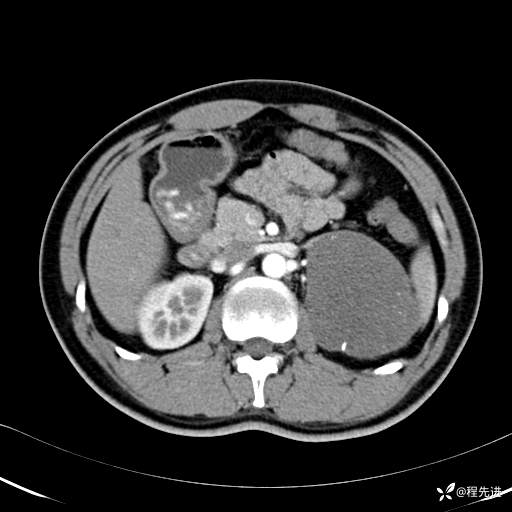
img
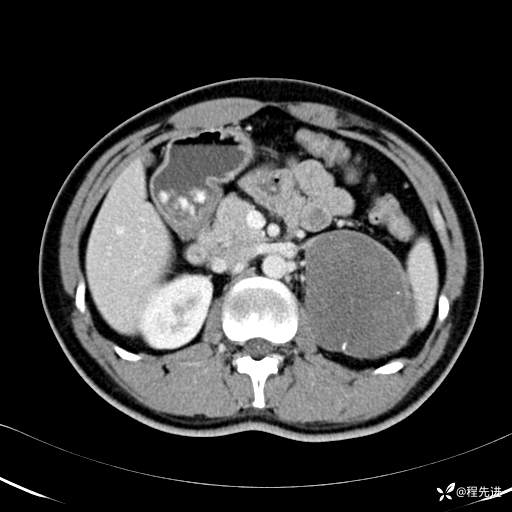
img
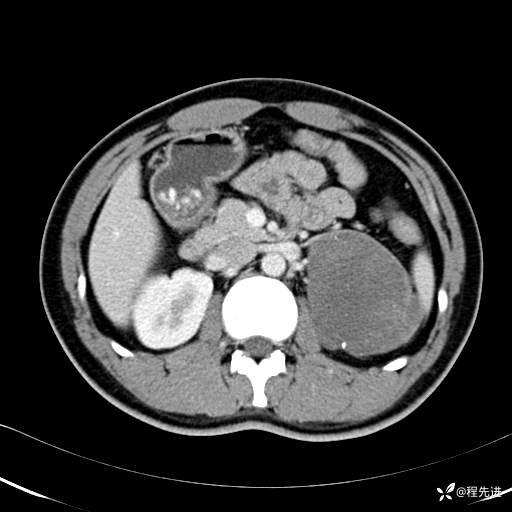
img
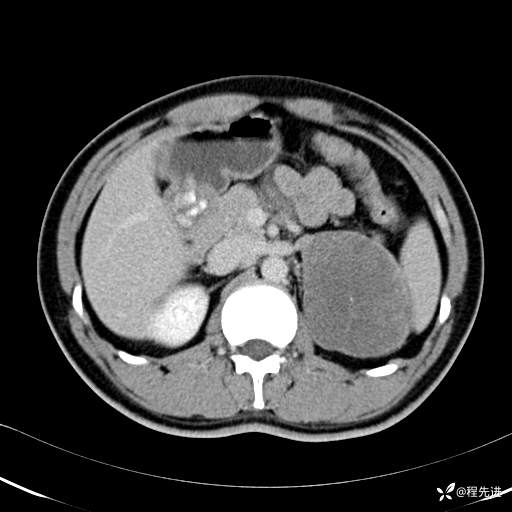
img
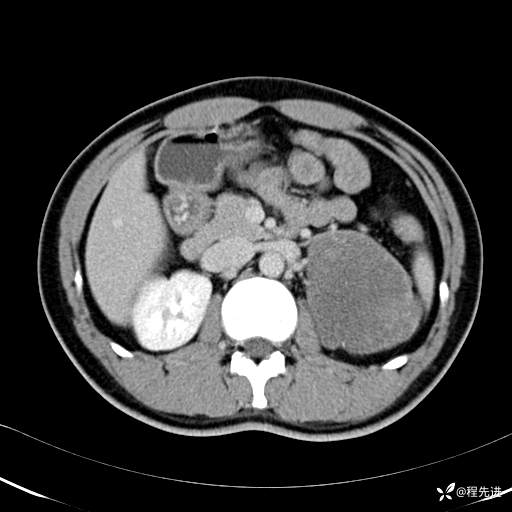
img

【腹盆】特别精彩病例|体检发现的左侧腹膜后占位期待您的精彩解读
呱呱叫了 等 3 位达人已点赞患者性别:男
患者年龄:25岁
简要病史:体检发现
CT平扫:(CT值:平扫,27HU,动脉期,27HU,门静脉期,31HU,平衡期,32HU)













CT增强:
动脉期:













门静脉期:













平衡期:













冠状位重建:














矢状位重建:












期待您的精彩解读!
呱呱叫了 等 3 位达人已点赞患者性别:男
患者年龄:25岁
简要病史:体检发现
CT平扫:(CT值:平扫,27HU,动脉期,27HU,门静脉期,31HU,平衡期,32HU)

CT增强:
动脉期:

门静脉期:

平衡期:

冠状位重建:














矢状位重建:












期待您的精彩解读!
